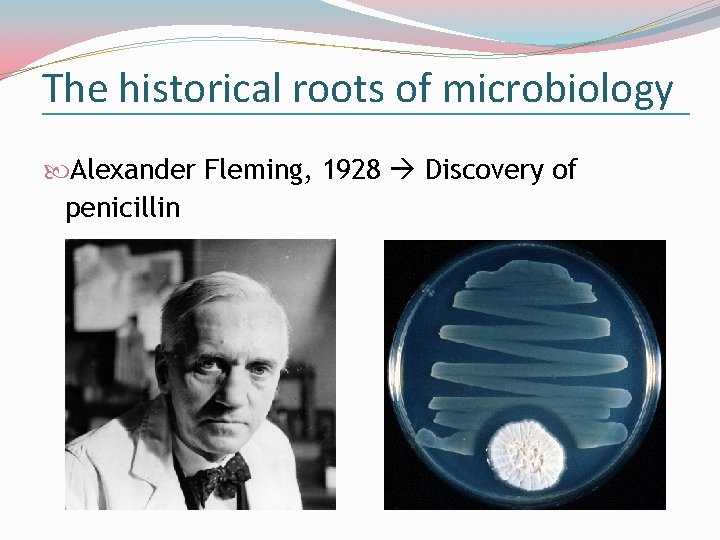
The historical roots of microbiology Alexander Fleming, 1928 Discovery of penicillin

Microbial World and Classification of Microorganisms Assist Prof

Microbial World and Classification of Microorganisms Assist. Prof. Emrah Ruh NEU Faculty of Medicine Department of Medical Microbiology

Microbial world Microorganism: A microscopic organism consisting of a single cell or cell cluster, including the viruses Microbiology: Study of microorganisms Medical microbiology: Study of microorganisms that cause infectious diseases

Classification of living organisms Linnaeus, 1753 (two kingdoms): Plantae: Bacteria, fungi, algae, plants Animalia: Protozoa and higher animals Haeckel, 1865 (three kingdoms): Plantae: Multicellular algae and plants Animalia: Animals Protista: Microorganisms (bacteria, protozoa, algae, molds and yeasts)

Classification of living organisms Whittaker, 1969 (five kingdoms): Plantae: Multicellular algae and plants Animalia: Animals Protista: Protozoa and single-celled algae Fungi: Molds and yeasts Monera: All bacteria (prokaryotes)

Classification of living organisms Woese, 1977 (three domains): Bacteria (eubacteria): Prokaryotes Archae (archaebacteria): Prokaryotes Eukaryotes: Protozoa, algae, fungi, plants and animals Ribosomal RNA sequences Phylogenetic analysis

Classification of living organisms Prokaryotes Bacteria Archaea Eukaryotes Eukarya Protozoa Algae Plants Fungi Animals

Classification of living organisms

Classification of living organisms

Prokaryotes and Eukaryotes

Prokaryotes and Eukaryotes

Prokaryotes and Eukaryotes Characteristic Prokaryotic cell Eukaryotic cell Size of cell Typically 0. 2 -2. 0 mm in diameter Typically 10 -100 mm in diameter Nuclear membrane Absent Present Nucleolus Absent Present Membraneenclosed organelles Absent Present (lysosomes, Golgi complex, ER, mitochondria, and chloroplasts)

Prokaryotes and Eukaryotes Characteristic Prokaryotic cell Eukaryotic cell Cell wall Usually present; chemically complex When present, chemically simple Plasma membrane No carbohydrates; generally lacks sterols Carbohydrates and sterols are present Ribosomes 70 S 80 S DNA Single circular Multiple linear chromosome; lacks chromosomes; histones are present

Prokaryotes and Eukaryotes Characteristic Prokaryotic cell Eukaryotic cell Cell division Binary fission Mitosis Sexual reproduction No meiosis; transfer of DNA fragments only Involves meiosis Cellular respiration Cell membrane Mitochondria Endospore formation Present Absent

Prokaryotes: Bacteria and archae Bacteria (eubacteria): Bacteria that are most familiar to microbiologists (disease-causing bacteria, soil and water bacteria, and photosynthetic bacteria) Archae (archaebacteria): Bacteria that produce methane gas, require very high levels of salt, or require very high temperatures

Symbiosis

Symbiosis Mutualism (+/+): Reciprocal benefit Commensalism (+/0): One organism gets benefit; the other organism gets neither benefit nor harm Parasitism (+/-): One organism gets benefit; the other organism gets harm

The impact of microorganisms on humans �Agriculture �N 2 fixation, nutrient cycling… �Food preservation, fermented foods… �Biotechnology �Production of pharmaceuticals…

The impact of microorganisms on humans Normal flora of human body Bacteria: protection against infectious microorganisms

Microbial world

Microbial world Microorganisms of medical importance: Prokaryotes Bacteria Eukaryotes Fungi Protozoons Viruses

Microbial world Scope of medical microbiology: Bacteriology Bacteria Mycology Fungi Parasitology Parasites (protozoons and helminths) Virology Viruses Immunology Immune system

The historical roots of microbiology Robert Hooke, 1664 Molds

The historical roots of microbiology Antoni van Leeuwenhoek, 1684 Microscope; “animalcules”; first to see bacteria and protozoons

The historical roots of microbiology �Louis Pasteur (1822 -1895): Downfall of “spontaneous generation” (some life forms arise spontaneously from non-living matter) �Organisms found in putrefying materials originate from microorganisms present in the air

The historical roots of microbiology �Robert Koch (1843 -1910): �Experimental support of “germ theory of disease” (proof that microorganisms can cause disease); “Koch’s postulates” �Growth of bacteria on solid media �Demonstration of the agent of tuberculosis
The historical roots of microbiology Alexander Fleming, 1928 Discovery of penicillin

The historical roots of microbiology John Enders, 1946 Cultivation of viruses in cell cultures
- Slides: 27